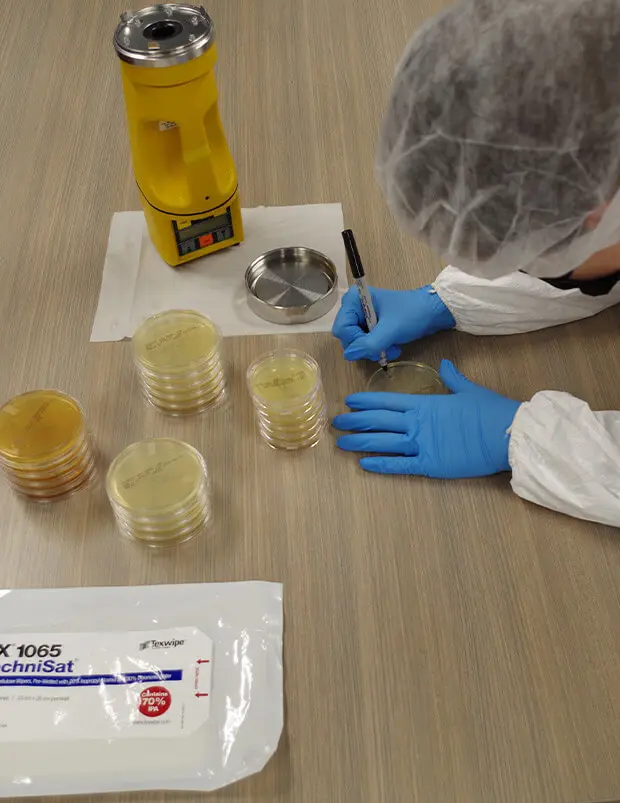
Environmental-Testing

Certification & Testing
Certification & Testing
Verified Performance. Documented Compliance. Trusted Results.
CERTS and ALA, divisions of Hodess, provide comprehensive cleanroom testing, commissioning, certification, and compliance services for critical and controlled environments. Our experienced certification professionals support facilities throughout construction, commissioning, and ongoing operations, ensuring cleanrooms, equipment, and support systems perform as designed and meet regulatory requirements.


Cleanroom & Facility Performance Testing.
- Cleanroom performance testing and ISO certification
- Airborne particle counts (non-viable) per ISO 14644
- Airflow volume, velocity, parallelism, and recovery testing
- Room pressurization, temperature, and relative humidity
- HEPA filter integrity testing and leak scans
- Surface particle quantification and characterization
- Light level, sound, vibration, ionization, EMI, and floor conductivity testing
- Operating room suite testing
- Make-up air handler and return air handler testing
- Room envelope pressure testing
- Innovative testing procedures for dry room operational performance
- Material testing to verify use in specific facilities
Equipment Certification & Safety Testing.
- Laminar airflow workstations (clean benches)
- Biological safety cabinets (BSCs)
- Chemical and ductless fume hoods
- Isolators, RABS, glove boxes (CACI / CAI)
- EFEM testing and certification
- Containment ventilation equipment (CVE)
- Vivarium biosafety enclosures
- HEPA filter replacement, service, and repair

USP & cGMP Compliance Services.
- USP <797>, <800>, <795>, and <825> testing and compliance readiness
- Viable (microbial) air and surface sampling
- Airflow visualization and streamer studies and CFD modeling
- Pressurization differential verification
- Decontamination services
- Consulting support for inspections and audits
Environmental Monitoring & Data Services.
- Viable air and surface sampling
- Bacterial and fungal identification, including gram stain testing
- Microbial and particulate trend analysis
- Non-viable particulate monitoring
- Guidance on alert and action limits
- Data logging for trend establishment and review
- Media agar supply for customer-performed sampling


Calibration & Specialty Services.
- On-site laboratory equipment calibration
- Temperature, RH, pressure, airflow, and gas systems
- Calibration of gauges, incubators, scales, pipettes, sensors, and automation systems
- Services performed in compliance with ANSI Z-540 and ISO 17025
- NIST-traceable, GxP-compliant documentation
Why Choose Hodess?
Our certification staff is trained and experienced in compliance with the latest industry standards, including ISO 14644, ISO 17025, NSF-49, IEST, CNBT/CAG, and USP 797/800/795/825. We deliver accurate testing, clear documentation, and dependable support, helping clients maintain compliance, protect operations, and stay inspection-ready.
ALA Microbial Services (ALA) complements CERTS by offering viable air/surface testing, production testing, and performance verification and validation testing to allow facilities to test their environments to ensure specific requirements are met. Our test labs are certified at ISO 7 with ISO 5 hoods that are constantly recertified and viability tested to ensure our work does not contaminate your samples. Each lab is run by a licensed hygienist.
Hodess certifies with confidence because performance must be proven.


